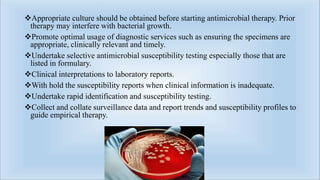
Appropriate culture should be obtained before starting antimicrobial therapy. Prior
therapy may interfere with bacterial growth.
Promote optimal usage of diagnostic services such as ensuring the specimens are
appropriate, clinically relevant and timely.
Undertake selective antimicrobial susceptibility testing especially those that are
listed in formulary.
Clinical interpretations to laboratory reports.
With hold the susceptibility reports when clinical information is inadequate.
Undertake rapid identification and susceptibility testing.
Collect and collate surveillance data and report trends and susceptibility profiles to
guide empirical therapy.

This document outlines an Antibiotic Stewardship Program (ASP) and provides guidance on its implementation. It discusses the rising threat of antimicrobial resistance globally and in India. The goals of an ASP are to combat resistance, improve patient outcomes, safety and reduce costs. Key elements include establishing a multidisciplinary team, conducting surveillance of antibiotic use and resistance patterns, implementing guidelines and formulary restrictions, and optimizing antibiotic use through interventions like automatic substitution and de-escalation of therapy. Barriers to ASP include lack of infrastructure, data and clinician knowledge. Laboratories play an important role through rapid diagnostics and susceptibility testing to guide appropriate empirical therapy.